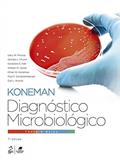
Ler Diagnóstico Microbiológico - Texto e Atlas Colorido, do autor Gary W. Procop Ler Diagnóstico Microbiológico - Texto e Atlas Colorido, do autor Gary W. Procop

Diagnóstico Microbiológico - Texto e Atlas Colorido não é apenas uma obra técnica; é um verdadeiro mapa de exploração pelo fascinante mundo do microbioma. Gary W. Procop, um gigante na microbiologia, transforma a complexa linguagem científica em uma experiência visual e didática, que desafia suas percepções e abre as portas para um entendimento profundo da vida invisível que nos rodeia!
Ao folhear as páginas deste texto monumental, você é imediatamente capturado por uma sinfonia de cores e detalhes que revelam a intricada estrutura dos microrganismos - criaturas tão poderosas que, muitas vezes, moldam o destino da saúde e da doença humana. Este não é apenas um atlas; é um compêndio que traz à tona um universo repleto de segredos, revelações e, acima de tudo, a urgência de conhecê-los.
Os leitores aclamam este trabalho pela sua capacidade de transformar o que poderia ser um conteúdo árido em uma experiência cativante. Comentários fervorosos narram como o livro se tornou um aliado indispensável em suas jornadas acadêmicas e profissionais. Críticas elogiosas sublinham a clareza didática, a riqueza visual e a profundidade científica que Procop consegue entregar. Neste livro, até mesmo aqueles que não têm formação específica na área se sentirão motivados a aprender, a entender e, quem sabe, até inspirados a mudar suas vidas!
A importância do Diagnóstico Microbiológico transcende a sala de aula e os laboratórios. Ele é um grito por conscientização em um tempo em que as doenças infecciosas ainda põem à prova a resistência do nosso sistema de saúde. O leitor se depara com conceitos vitais que moldam a compreensão da microbiologia moderna, e é impossível não se sentir compelido a refletir sobre o impacto dessas informações na saúde pública global.
Em um mundo que enfrenta pandemias e surtos, este livro se revela um guia essencial. A obra não se limita a descrever microrganismos; ela estabeleceu uma rede de conexões com a biologia, a medicina e até mesmo a filosofia - incitando o leitor a questionar: o que sabemos realmente sobre a vida ao nosso redor? O que significa conviver com seres tão pequenos, mas que têm um papel tão colossal?
A narrativa visual destila uma paixão intensa pela microbiologia. Cada ilustração funciona não apenas como um complemento, mas como um convite à descoberta. Você pode sentir a curiosidade borbulhar enquanto suas páginas se desdobram, revelando aqueles organismos que, embora invisíveis, têm o poder de transformar a nossa saúde ou devastar comunidades inteiras.
Ainda assim, não faltam vozes críticas. Alguns leitores apontam que, apesar da riqueza do material, a densidade do conteúdo pode ser desafiadora para iniciantes. Mas, oh, que ótimo desafio! É a oportunidade perfeita para mergulhar de cabeça em um universo que promete recompensas inestimáveis à medida que você aprende. É um testemunho da habilidade do autor em escrever não apenas sobre o que está no microscópio, mas também sobre a necessidade imperativa de entender e interagir com isso.
Diagnóstico Microbiológico - Texto e Atlas Colorido torna-se, assim, não só uma obra acadêmica, mas um chamado à ação. Uma palavra, um gráfico, uma ilustração: cada elemento se entrelaça para desafiar suas convicções e expandir sua mente. Através das páginas bem elaboradas de Procop, você não apenas aprende a ciência; você vive e respira o microbioma que permeia nossa existência. Este é um livreto que clama para ser explorado, debatido e, acima de tudo, absorvido - porque o que está em jogo é a compreensão do que significa estar vivo.
📖 Diagnóstico Microbiológico - Texto e Atlas Colorido
✍ by Gary W. Procop
🧾 1663 páginas
2018
#diagnostico #microbiologico #texto #atlas #colorido #gary #procop #GaryWProcop